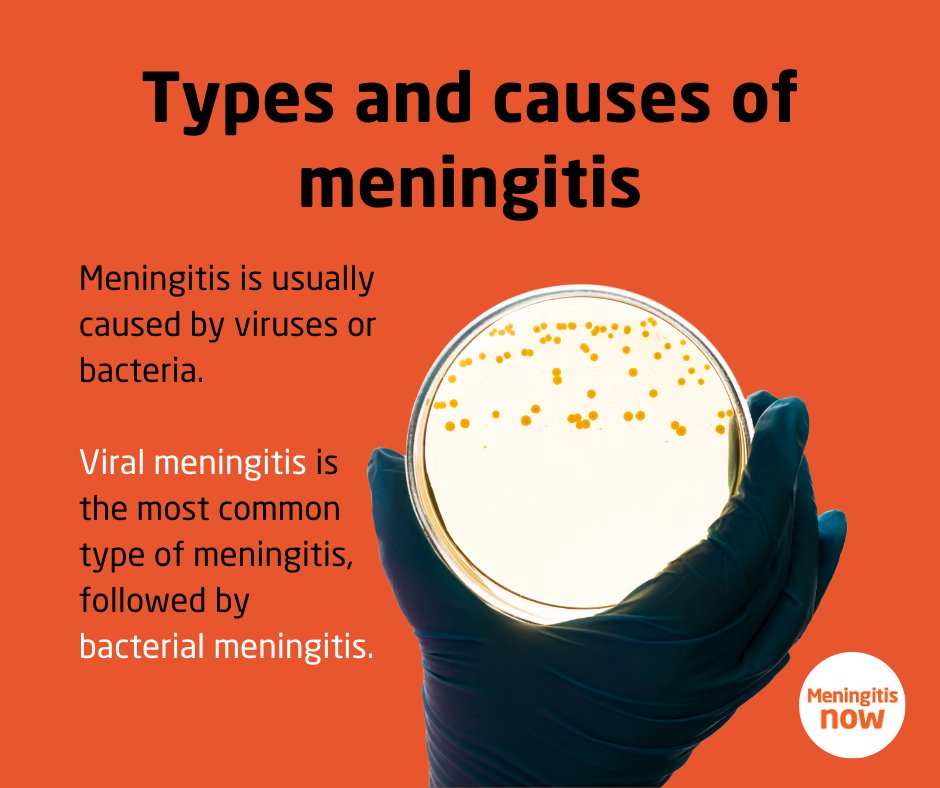
Meningitis is usually caused by viruses or bacteria. Viral meningitis is the most common type of meningitis, followed by bacterial meningitis. Rarer types of meningitis include chemical and fungal meningitis. 

Find out about the types of meningitis 👉 bit.ly/3iNdQDo

UCL Student Support and Wellbeing Services
@uclsupport
We are UCL Student Support and Wellbeing, helping you have a happy, healthy and balanced student life.
ID: 507415176
https://www.ucl.ac.uk/students/student-support-and-wellbeing 28-02-2012 14:03:34
3,3K Tweet
4,4K Takipçi
593 Takip Edilen


UCL is ranked among the top 10 universities worldwide for the 12th year running, in the 2024 QS World University Rankings! 👏 #QSWUR QS World University Rankings ucl.ac.uk/news/2023/jun/…
















Are you looking to be more savvy with your money? As part of National Student Money Week (4 - 8 March) UCL Funding are running events throughout the week to help UCL students learn more about their financial wellbeing and how to save money. Learn more: ucl.ac.uk/students/news/…